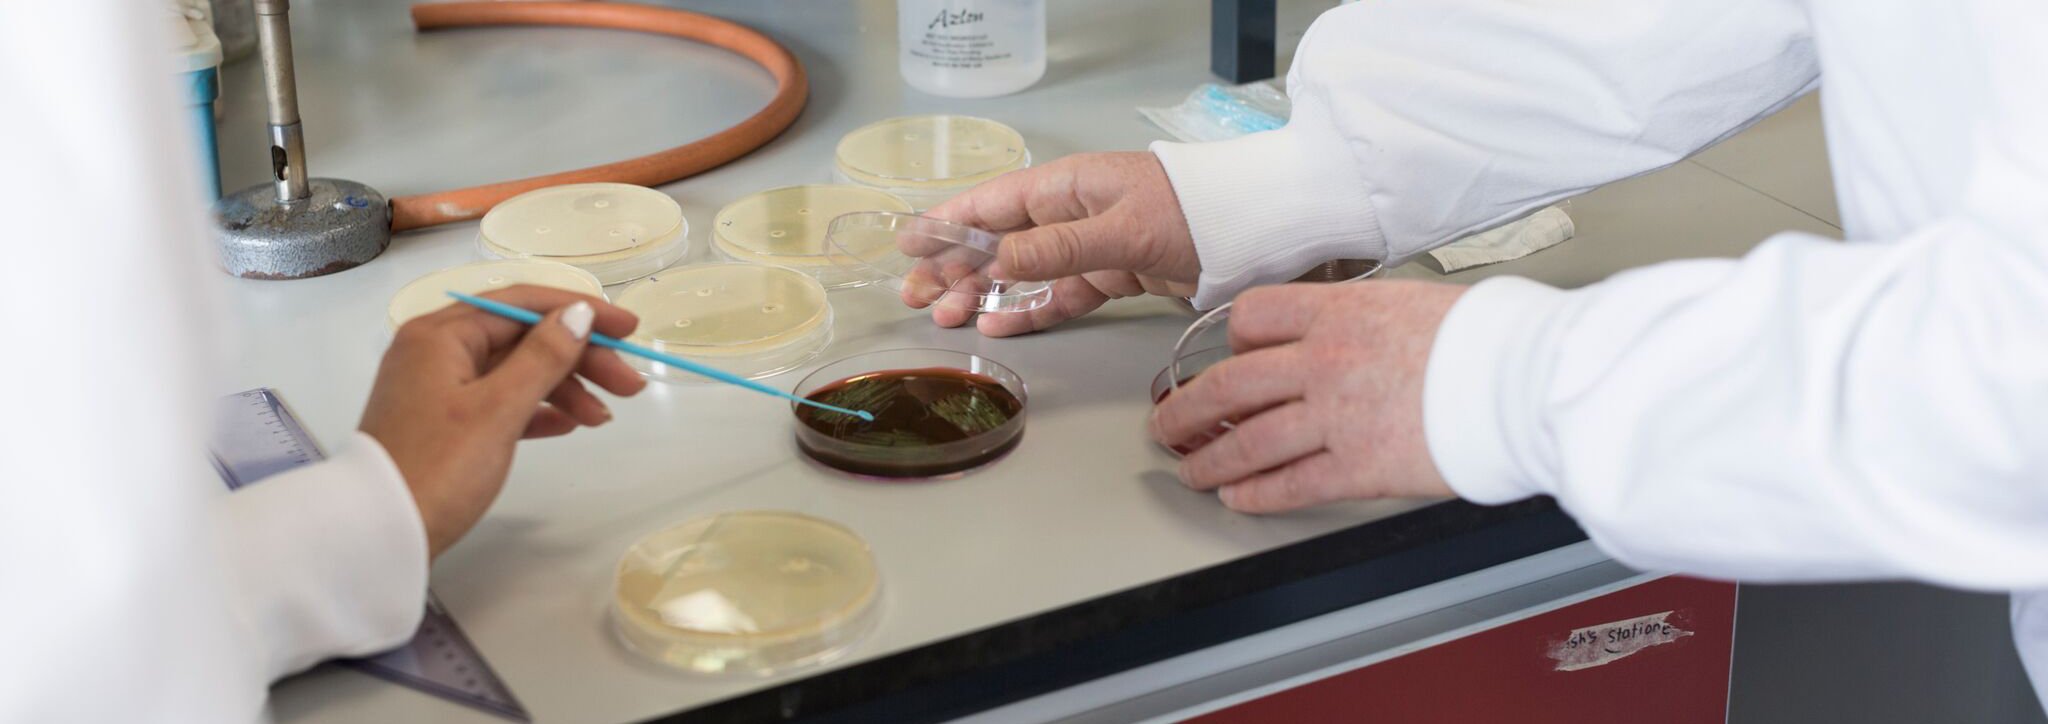

Kathleen Lonsdale Institute for Human Health Research, in the 21st century, the prevalence of chronic illness, the emergence of new diseases and the persistence of recalcitrant global infections will demand innovative ways to combat disease.
Research at Maynooth University is focused on understanding the fundamental aspects of health and disease.
Our research teams collaborate with international academics, healthcare providers and industry to explore unique aspects of human health at the molecular and cellular levels, discovering new ways to tackle disease, and to translate our discoveries into novel medicines, procedures and policies.